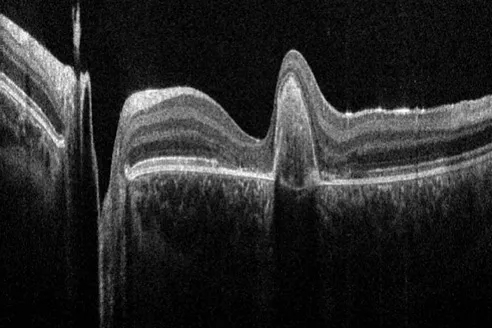

2024年是徠卡顯微成立第175周年。
這175年,既是徠卡品牌的發展歷程,也是世界光學顯微技術的發展史。
這175年,徠卡始終滿懷熱忱,以創新將可視化、分析能力推向更高更遠。徠卡的愿景是瞰見未知,賦能客戶,同創世界健康與美好。
讓我們共同回顧
徠卡品牌走過的百年風雨歷程
感受人類在光學顯微技術領域的不斷開拓創新
1849 - 2004年
品牌早期歷程
1849年
德國數學家卡爾·凱爾納 (Carl Kellner) 博士在德國韋茨拉爾成立 Optical Institute 光學公司,開始鏡頭與顯微鏡的研究。

早期的徠卡顯微鏡工廠
1853年
Optical Institute在美國成立 Bausch & Lomb 儀器部門。
1865年
恩斯特·徠茲一世 (Ernst Leitz I) ,加入了公司并成為公司的合伙人。

恩斯特·徠茲一世 (Ernst Leitz I)
1869年
Ernst Leitz 接管“Optical Institute”并將公司改名為“Ernst Leitz”。

早期的Leitz徠茲顯微鏡
1872年
Rudolf Jung在德國的海德堡成立精密工程公司。一個世紀以后,海德堡將誕生一家培養了十多位諾貝爾獎得主的全球著名研究所——歐洲分子生物學實驗室EMBL(European Molecular Biology Laboratory)。

魯道夫·榮格 (Rudolf Jung)
1876年
C. Reichert在奧地利的維也納成立光學公司。

卡爾·賴希特 (Carl Reichert)
上述兩家公司后來合并為Reichert-Jung。

1881年
霍勒斯·達爾文 (Horace Darwin) 創立劍橋儀器光學公司 (Cambridge Instruments),該公司也是徠卡集團的前身之一。而霍勒斯·達爾文的父親,正是《物種起源》的作者,進化論的奠基人,英國生物學家查爾斯·達爾文 (Charles Darwin)。

霍勒斯·達爾文 (Horace Darwin)


查爾斯·達爾文 (Charles Darwin),進化論之父
1907年
徠卡將第10萬臺量產顯微鏡贈予諾貝爾獎獲得者羅伯特·科赫 (Robert Koch)。羅伯特·科赫是德國科學家,因發現結核桿菌及細菌學相關研究而獲得諾貝爾醫學獎,被譽為“細菌學之父”。

羅伯特·科赫
(Robert Koch)

徠卡贈送給羅伯特·科赫的顯微鏡

羅伯特·科赫
在使用徠卡顯微鏡
1913年
徠卡推出首臺雙目筒顯微鏡。

首臺雙目筒顯微鏡
1914年
奧斯卡·巴納克 (Oskar Barnack) 發明 Leitz 35 mm 小畫幅相機。由此開啟了相機界的頂流——Leica徠卡相機的歷史。

第一臺徠卡相機UR-LEICA
1921年
Wild Heerbrugg在瑞士創建光學公司。

海因里希·懷爾德 (Heinrich Wild)
1925年
徠卡推出首臺偏光顯微鏡。

1929年
徠卡發布光子顯微鏡。
1932年
徠卡推出入射光熒光顯微鏡。


1950年代的徠卡顯微鏡工廠
1967年
徠卡發布圖像分析產品 (定量分析顯微鏡) 。
1972年
Leitz Wetzlar 和 Wild Heerbrugg 開始合作。

1976年
公司拓展金屬材料研究業務,并收購了達爾文創立的Cambridge Instruments(首家掃描電子顯微鏡制造商)。
1981年
Wild Leitz 集團開始規劃成立。

1984年
ELSAM 超聲顯微鏡榮獲德國商業創新獎。
1986年
Ernst Leitz 和 Wild Heerbrugg 合并成立 Wild Leitz 集團。
1990年
Wild Leitz、Cambridge Instruments、Reichert & Jung 和 Bausch & Lomb 合并成立徠卡集團。

1993年
徠卡集團在中國設立第一家樣本制備合資公司。
1998年
徠卡集團的徠卡相機、徠卡顯微系統和徠卡測量系統三大業務單元成為三家獨立公司。



2003年
徠卡 DUV 物鏡獲得德國商業創新獎。
2004年
第一臺超分辨率共聚焦 (4Pi) 顯微鏡。
2005 - 2014年
加入丹納赫
繼續引領世界光學顯微技術發展
2005年
徠卡顯微系統正式加入美國丹納赫(Danaher)集團,成為丹納赫生命科學平臺的一個重要分支。

丹納赫是全球科學和技術的創新者,徠卡與之攜手,加速科技對今日生活之影響,改善人類健康。
2005年大事記
推出創新激光顯微切割系統
TCS SP5共聚焦顯微鏡面世,具備當時單臺共聚焦顯微鏡有史以來最高的成像速度和分辨率
AF6000 LX集成系統適用于高級寬場熒光成像和分析,使研究人員能夠在幾天內通過快速細胞動力學成像或 4D 實驗來研究生命過程。

徠卡 LMD6000 可處理較厚的樣本和較硬的材料
2006年大事記
徠卡推出組織病理學網絡解決方案
徠卡顯微系統公司第三次獲得“Innovationspreis”(德國商業創新獎)
2007年大事記
徠卡與超高分辨率技術之父斯特凡·黑爾 (Stefan Hell) ,推出超越當時顯微分辨率極限的TCS STED 光學顯微鏡。這是世界首款商用STED顯微鏡,光學分辨率小于90納米。

Max Planck Innovation 簽署 RESOLFT 技術的許可證協議;哈佛大學科技發展辦公室向徠卡授予其 CARS 顯微鏡技術許可證。
徠卡顯微系統公司新成立生物系統部門,后來發展為丹納赫集團診斷平臺旗下運營公司。

徠卡推出M165 C和M205 C高端體視顯微鏡,采用 FusionOptics 融合光學技術,樹立了體視顯微鏡領域的新標桿。

2008年大事記
徠卡顯微系統公司成為總部設于德國海德堡的歐洲分子生物學實驗室 (EMBL) 高級培訓中心的創始合作伙伴。而德國海德堡正是徠卡公司的前身之一——1872年魯道夫·榮格 (Rudolf Jung)的精密工程公司——成立的地方。

徠卡推出 M720 OH5 是小巧的神經外科顯微鏡,配有水平光學系統,采用移動設計理念,具有出色的頭頂操作性。
徠卡顯微系統公司憑借 FusionOptics 融合光學技術贏得 PRODEX 獎項,該技術能夠形成高分辨率、更大景深、3D效果更佳的圖像。
徠卡 TCS SP5 X 超連續譜共聚焦顯微鏡榮獲2008年度《科學家》雜志十大創新獎。

2009年大事記
Max Planck Innovation 為徠卡顯微系統的全新 GSDIM(緊隨基態淬滅顯微技術的單分子返回)超分辨率技術頒發獨家許可證。
徠卡 SCN400 玻片掃描儀為病理學、研究和教學中的組織學樣本檢查顯微鏡提供了替代產品。
徠卡推出Cleanliness Expert 多合一清潔度分析系統,用于在汽車制造業生產過程中測量微機械和發動機組件的清洗液中的雜質含量。
2010年大事記
徠卡顯微系統公司在年度互聯世界大會上獲得 M2M 價值鏈金獎,Axeda Corporation 被譽為徠卡獲得此獎項的一大助力。
徠卡生物系統公司獲得研究和咨詢公司Frost & Sullivan頒發的北美組織診斷產品戰略獎。
Kavo Dental 和徠卡顯微系統在牙科顯微鏡領域開展合作。

2011年大事記
徠卡生物系統公司榮獲2011年度卓越制造 (MX) 獎。
學習、分享、貢獻。科學實驗室 (Science Lab) 正式上線,為用戶提供文章、訪談、教程和網絡研討會,截至2023年已累計上線500多篇內容。

2012年大事記
徠卡 GSD 超分辨率顯微鏡獲得三項大獎:《R&D》雜志為卓越技術創新頒發的百大科技研發獎、相關的三項“編輯選擇獎”之一、美國雜志《今日顯微鏡》(Microscopy Today) 頒發的2012度十大創新獎。
德國韋茨拉爾的徠卡顯微系統運營部門由于采用看板管理體系而榮獲“物流和運營管理”卓越制造獎。
徠卡推出TCS SP8共聚焦顯微鏡集高性能光學器件、快速的真共焦掃描儀和最靈敏的檢測系統于一身,協助研究人員探索生命的奧秘。
2013年大事記
徠卡SR GSD 3D超分辨率顯微鏡被評選為2013年實驗室和研究領域十大創新之一。該儀器基于GSDIM/dSTORM3,使科學家能夠看到并研究分子層面的細胞結構和過程。

徠卡推出集成 TrueVision 3D 技術的手術顯微鏡,使整個手術團隊無需單獨的設備推車就可以看到外科醫生所看到的情況,從而節省手術室空間。
2014年大事記
超分辨率顯微鏡之父斯特凡·黑爾 (Stefan Hell) 榮獲諾貝爾獎。

徠卡 TCS SP8 STED 3X 榮獲兩大獎項:《科學家》雜志十大創新獎和《R&D》雜志百大科技研發獎均將超分辨率顯微鏡評定為改變生命科學家工作方式的創新成果之一。

徠卡推出M530 OH6手術顯微鏡,所采用的技術能幫助外科醫生更清晰地觀察深而窄的空腔。
徠卡推出平臺化的DMi8倒置顯微鏡。研究人員從此能夠完全以模塊化方式構建自己的顯微系統。該平臺可隨時根據需求進行調整,這一點與從前的儀器截然不同。
日本宇宙航空研究開發機構的宇航員若田光一 (Koichi Wakata) 使用徠卡 DMI6000 B 研究用倒置顯微鏡在國際空間站進行了活細胞實驗。

2015-2024年
加速創新,不斷樹立市場標桿
2015年大事記
徠卡電鏡制樣團隊推出EM ICE高壓冷凍儀。從推出首臺到2021年推出EM ICE,徠卡在電子顯微鏡樣品制備領域已累積了超過145年的經驗。

劃時代的Leica EM ICE高壓冷凍儀

第一臺超薄切片機
徠卡顯微系統公司收購光學相干斷層掃描 (OCT) 公司 Bioptigen,徠卡光學相干斷層掃描系統通過易于使用的高質量成像技術為眼科醫生、眼外科醫生和研究人員提供支持。
徠卡推出內置無線攝像頭的徠卡EZ4 W教學用體視顯微鏡和徠卡ICC50 W數碼攝像頭可將高清圖像直接傳送到學生的移動設備。

2016年大事記
徠卡顯微系統公司獨家獲得了哥倫比亞大學 SCAPE 生命科學應用顯微技術許可證;還獨家獲得了倫敦帝國理工學院 (Imperial College) 的斜面顯微鏡 (OPM) 許可證。
徠卡EZ4 W教育用體視顯微鏡獲得世界教具聯合會 (Worlddidac) 大獎。

徠卡推出CaptiView 技術,可將來自圖像導航手術 (IGS) 軟件的圖像注入顯微鏡目鏡。
2017年大事記
全球首個可調光譜深度成像解決方案誕生---徠卡 SP8 DIVE。
徠卡推出DMI8 S,以前所未有的方式查找、觀察活細胞并與其互動,為獲得超分辨率和納米顯微成像而添加的 Infinity TIRF 模塊能夠以單分子分辨率同時進行多色成像,由此開啟寬視場成像的新篇章。

2018年大事記
徠卡推出LIGHTNING技術,重新定義共聚焦成像的檢測極限 — 從精細結構中提取有價值的圖像信息。

徠卡推出SP8 FALCON快速熒光壽命對比系統,壽命對比記錄速度比以前的解決方案快10倍。這一壽命信息使研究人員能夠監控活細胞中蛋白質之間的相互作用。

徠卡推出ARveo 數字化增強現實神經外科顯微鏡可為外科醫生提供廣泛的視覺信息,幫助他們在手術中做出決定。

ARTOS 3D 標志著超薄切片機切片質量和速度的新水平。ARTOS 3D 自動制作非常一致的超薄切片帶(納米級厚度),用于對樣本進行陣列斷層掃描 3D 圖像重建。

隨著 PROvido 多科室顯微鏡的推出,徠卡顯微系統公司在廣泛的外科應用中增強了術中成像能力。PROvido 配備徠卡顯微系統公司獨有的 FusionOptics 融合光學技術,該技術以前僅用于高端顯微鏡解決方案。
2019年大事記
實現 3D 生物學相關樣本寬視場成像,THUNDER 成像系統使用戶能夠實時清晰地看到生物學相關模型(例如模式生物、組織切片和 3D 細胞培養物)厚樣本內部深處的微小細節。實現3D生物學相關樣本寬視場成像。

2020年大事記
推出新一代共聚焦STELLARIS是一個經徹底重新設計的共聚焦顯微鏡平臺,可與所有徠卡模塊(包括FLIM、STED、 DLS和CRS)結合使用。

術中光學相干斷層掃描(OCT)成像系統EnFocus誕生,它能提供更多的實時信息,有利于在眼外科手術中更深入地了解表面下的組織對手術操作的反應。

2021年大事記
徠卡推出Cell DIVE 超多標組織成像分析整體解決方案,Cell DIVE超多標組織成像分析整體解決方案是基于抗體標記的超多標平臺,適用于癌癥研究。多標或者超多標成像是清晰地觀察、識別和量化重要生物標志物的技術。

徠卡推出新品數碼顯微鏡Emspira 3系統,該產品榮獲2022年紅點產品設計大獎,不僅采用創新的模塊化設計,而且提供廣泛的配件和照明選項。

徠卡將領先的顯微圖像分析工具Aivia納入旗下。Aivia采用先進的算法和軟件架構,能夠在顯示大型圖像和分析復雜生物現象等關鍵任務上提供出色的性能。

2022年大事記
徠卡創新推出Mica多模態顯微成像分析中樞,讓所有生命科學研究人員都能理解空間環境。

徠卡發布具有高精度共聚焦三維目標定位功能的Coral Cryo工作流程解決方案。Coral工作流程解決方案包括一臺配備冷凍臺和傳送梭的STELLARIS 5 Cryo共聚焦顯微鏡,使研究人員能夠提高冷凍電子斷層掃描實驗的成功率。

2023年大事記
徠卡Mateo TL 數字化倒置顯微鏡上市,檢查培養細胞輕松搞定。

2024年大事記
全新一代超薄切片機UC Enuity上市,進一步提升的控制精度結合自動化模塊,使您能夠輕松獲得高效優質的超薄切片。

超高分辨率顯微鏡更新TauSTED Xtend技術,在令人矚目的納米尺度上擴展多色實時成像能力。

5月,徠卡顯微系統宣布正式將先進的光片顯微技術公司Viventis納入旗下。其最新產品Viventis LS2 Live結合了多視野和多位置光片成像技術,將幫助客戶同時觀察多個活體樣本。

6月,德國韋茨拉爾:徠卡顯微系統,作為顯微鏡和科學儀器領域的前沿制造商,宣布推出Aivia 14,即公司的第14版旗艦級人工智能圖像分析軟件。

2024年下半年,
徠卡顯微系統還將發布
多款新品和革命性技術,盡請期待。
展望下一個175年
作為丹納赫集團的一員,徠卡顯微系統將繼續以“生命不息,創新不止”為使命,推出更多幫助客戶開拓“新視界”的光學顯微產品和解決方案。
作為全球光學顯微技術的領先者,徠卡顯微系統將繼續堅持“From Eye to Insight”,以“洞幽察微,賦能客戶,讓世界更加健康美好”為愿景。
我們將著眼未來,以全新的數字化和人工智能技術賦能顯微技術創新,繼續助力生命科學研究、醫療健康、半導體微電子、新能源、材料分析等眾多領域的發展。
了解更多:徠卡顯微